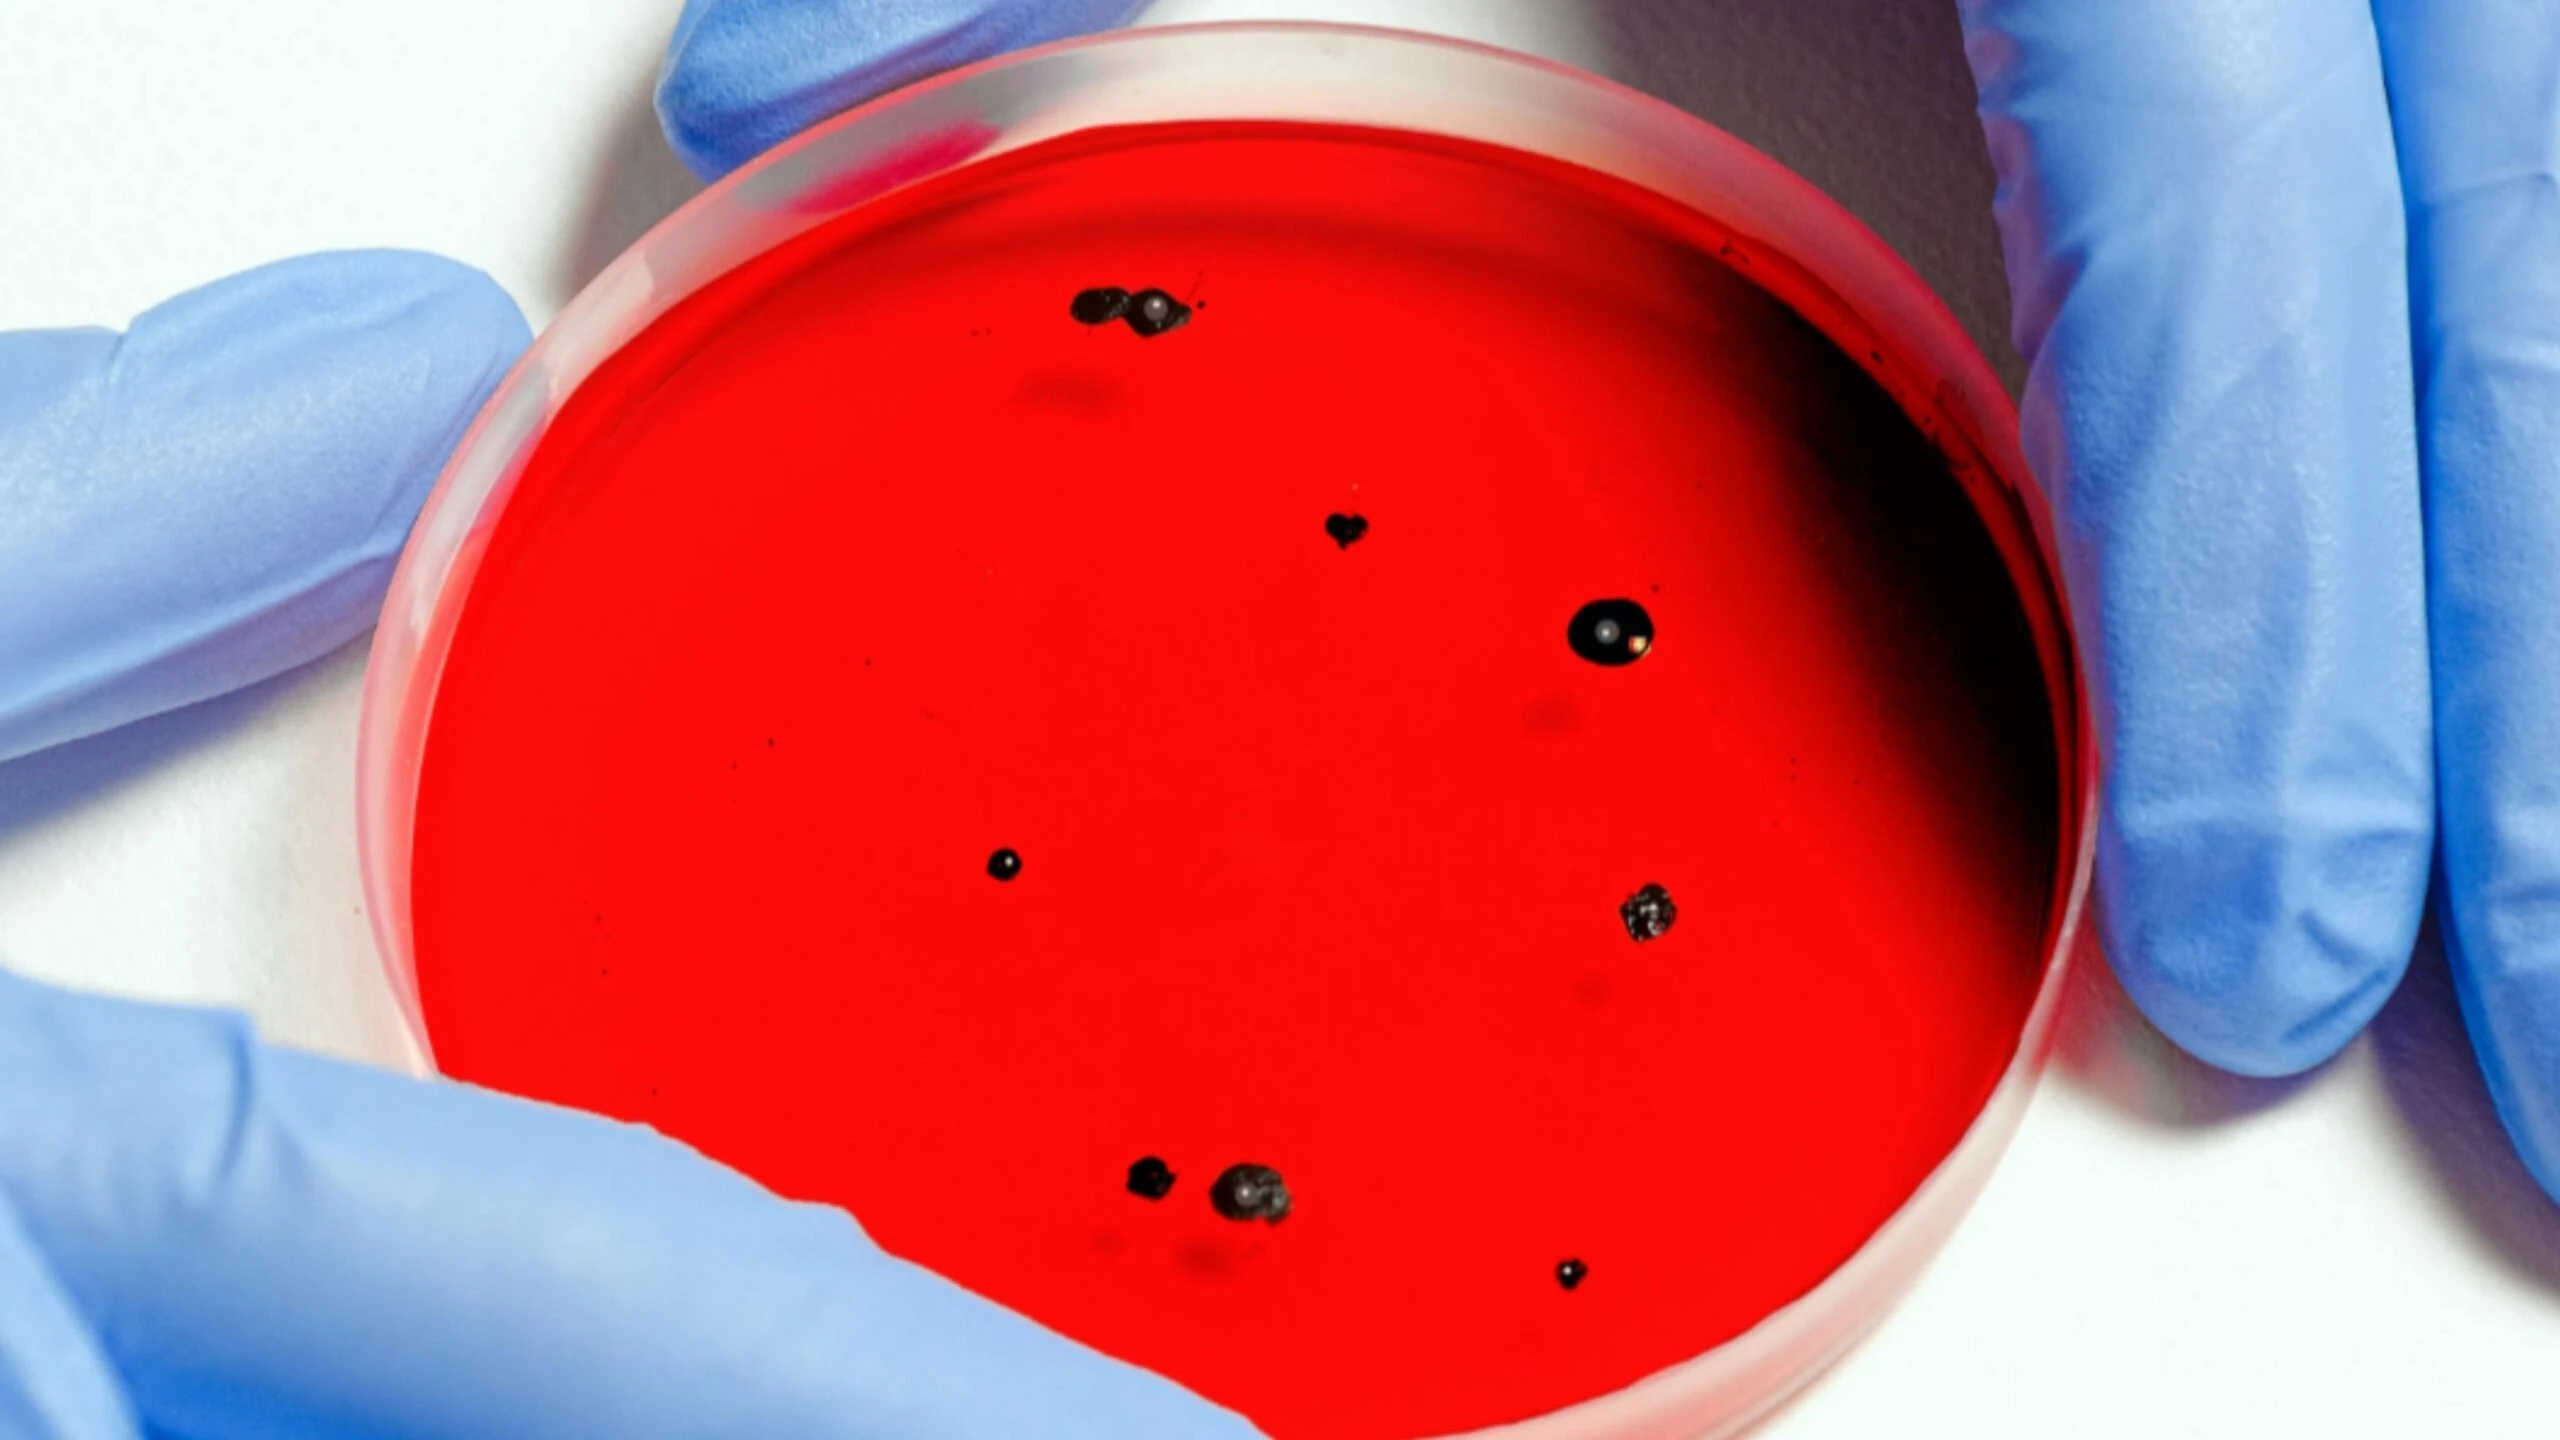
Adsiz tasarim 80 1 scaled

Kandaki iltihabı temizleyen en etkili çay! Enfeksiyon riskini azaltıyor
Son zamanlarda bağışıklık sistemine yönelik aramalar hız kazandı. Yorgunluk, geçmeyen ağrılar ve daha çok hastalanma şikayetleri giderek fazlalaşırken, gözler şimdi kandaki iltihap seviyelerine çevrildi. Peki kanda iltihap olunca ne olur ve kandaki iltihap nasıl düşürülür? İşte enfeksiyon riskini azaltan ve kandaki iltihabı temizleyen en etkili çay...

Kandaki iltihap, son zamanlarda sadece doktorların ilgi çektiği bir konu değil, sürekli yorgunluk ve hastalıkla mücadele edenlerin de merak ettiği konu haline geldi. ‘CRP neden yükselir?’, ‘Kanda iltihap nasıl düşürülür?’, gibi sorular arama motorlarında sıkça sorgulanıyor. Kandaki iltihabı temizleyen etkili bir çay özellikle bağışıklığı güçlendirerek, iltihap sürecini dengeliyor. İşte enfeksiyon riskini azaltmaya yardımcı olan ve kandaki iltihabı en etkili ve hızlı temizleyen yeşil çayın faydaları…
KANAKİ İLTİHABI TEMİZLEYEN EN ETKİLİ ÇAY! ENFEKSİYON RİSKİNİ AZALTIYOR
Yeşil çay, içeriğinde bulunan antioksidanlar nedeniyle kandaki iltihap sürecini dengeleyen bitkisel içeceklerin başında geliyor. Yeşil çayın içinde bulunan epigallokateşin gallat adındaki bileşen, serbest radikallerle savaşıyor ve adeta iltihaba karşı koruyucu bir kalkan görevi görüyor. Yeşil çay düzenli tüksetildiği zaman, bağışıklığı güçlendirdiğinden, enfeksiyonlara karşı vücut mekanizması da güçleniyor.

KANDAKİ İLTİHABI EN İYİ NE TEMİZLER?
Kandaki iltihabı azaltma konusunda yeşil çay oldukça etkili olsa da bunun yanında zerdeçal, zencefil, omega-3 bakımından zengin besinler de oldukça etkilidir. Düzenli uyku, yeteri kadar su içmek ve stresten uzak durmak da iltihap seviyelerini düşürme de yardımcı oluyor.

YEŞİL ÇAYIN FAYDALARI NELERDİR?
Yeşil çay, son yıllarda özellikle vücuttaki iltihaba karşı oldukça tercih ediliyor. Düzenli tüketilen yeşil çay, bağışıklık sistemine de doğrudan etki ediyor. Ayrıca yeşil çay hücrelerin kendini yenilemesini sağlıyor ve sindirime de oldukça etkili. Kış aylarında özellikle yeşil çay tüksetilmesinin sebebi yine vücut direncini artırıcı özelliği olmasından kaynaklanıyor.

KANDAKİ İLTİHAP CRP KAÇ OLMALIDIR?
Knada iltihap seviyesini gösteren CRP’dir. Genel olarak sağlıklı bir bireyde CRP değeri 5 mg/L’nin altında olmalıdır. CRP’nin 10 mg/L’nin altında olan normal sınırlar içinde kabul ediliyor. Ancak 10 ila 100 mg/L’nin arasında olanlar orta düzey, 100 mg/L’nin üzerinde olanlar ise ciddi bir enfeksiyon ve yoğun iltihaplanma seviyesinde olduğundan acil müdahaleye alınmalıdır.

KANDA İLTİHAP OLUNCA NE OLUR?
Kanda iltihap olması durumunda bağışıklık sistemi de doğrudan alarm durumuna geçer. Kanda oluşan iltihaplanma sonrası yüksek ateş, halsizlik, tansiyon düşüklüğü ve çarpıntı görülebilir. Eğer tıbbi müdahale olmazsa, iltihap dokulara ve diğer organlara etki ederek, organ hasarına yol açabilir. Eğer süreç daha da ilerlerse, karaciğer, akciğer, böbrek ve kalp gibi hayati organlarda yetmezlik süreci başlar.

EN SIK SORULAN SORULAR VE CEVAPLARI
Kandaki iltihap yeşil çayla tamamen temizlenir mi?
Çaylar süreci destekler ancak tek başına yeterli olmaz.
Yeşil çay ne kadar sürede etkisini gösterir?
Yeşil çayın iltihap üzerindeki etkisi kişinin yaşamına ve bünyesine göre değişiklik gösterebilir.

Kandaki iltihabı düşürmek için ne yapmalı?
Yeşil çay tüketimi dışında kandaki iltihabı düşürmek için, dengeli beslenme, işlenmiş gıdalardan uzak durmak, lifli besinler tüketmek, meyve ve sebzeyi düzenli tüketmek gerekiyor. Ayrıca stresten uzak durmak da oldukça etkilidir.











